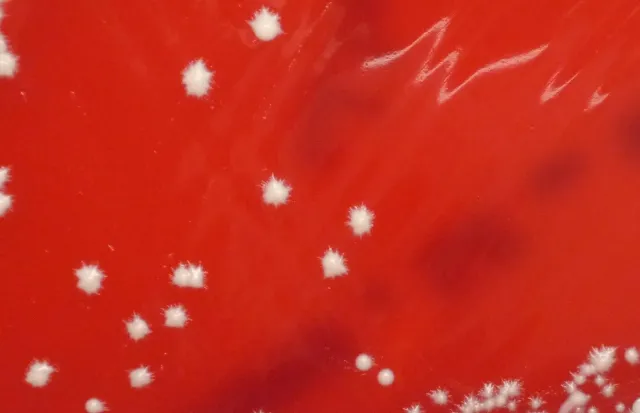
Star shaped candida albicans in Blood Agar - Star-shaped colonies ofCandida albicansin blood agar.

Candida albicans is an endogenous organism found in 40 to 80% of normal humans as commensal in the gastrointestinal tract, oropharynx, and female genital tract. It is a commonest cause of candidiasis (moniliasis). Other most common isolates of Candida species are Candida tropicalis, Candida parapsilosis, Candida glabrata, and Candida auris.

Morphological Characteristics
- Candida albicans is a gram-positive yeast with a single bud.
- In direct stained smear (of the pathogenic sample)**,**the yeasts can often be attached to pseudohyphae. Both the yeasts and pseudohyphae are Gram-positive. Pseudohyphae are elongated yeasts that visually resemble hyphae but are not true hyphae.
- Candida albicans also produces true hyphae when it invades tissues.
- Chlamydospores are typically formed by C. albicans but not by most other species of Candida. C. dubliniensis also forms chlamydospores but unlike C. albicans it will not grow at 42°C.
Some of the multiple choice questions test your knowledge regarding this fact; e.g., MCQs like, ‘all of the following organisms are dimorphic fungi except’; or ‘which of the following fungal pathogen is Gram positive in nature’.Reada blog post about dimorphic Fungi here
Pathogenesis
Intact skin and mucous membranes provide the first line of defense against Candida infections. Th-1 cells produce gamma-interferon that activates efficient killing by macrophages.
Most Candida infections are opportunistic, occurring when a patient has some alteration in cellular immunity, normal flora, or normal physiology. Infection may be caused by endogenous yeasts or may be nosocomial. Candidiasis is the most common fungal infection in HIV-infected individuals.
- The more debilitated the host, the more invasive the disease.
- Patients with neutropenia are at high risk of acquiring disseminated candida infections.
- Prolonged broad-spectrum antibiotic or steroid therapy predisposes to candida infections.
- Invasive procedures, e.g., surgery/ indwelling catheters, predispose to Candida.
Virulence Factors
- Fibronectin receptor on Candida albicans facilitates its adherence to the (fibronectin, a component of the host extracellular matrix) epithelium of the gastrointestinal or urinary tract.
- Hydrophobic molecule on the surface of Candida also helps in adhesion.
- Aspartyl protease found in C. albicans has shown increased ability to cause disease in animal models.
- Phenotypic switching and the presence of phospholipase also play a role in pathogenesis.
Because most people carryCandidaas part of the normal flora, skin testing withCandidaantigens can be used to determine whethercell-mediated immunityis normal.
Diseases
C.albicans is responsible for several infections in healthy and immunocompromised patients.
Overgrowth ofC. albicansproduces white ‘cottage cheese-like film’ called thrush. This form of candidiasis is known as pseudomembranous candidiasis and is the classic sign of acute infection.
Main diseases include;
- Oropharyngeal candidiasis (oral thrush): Common in those with HIV/AIDS.
- Vulvovaginal candidiasis (vaginal thrush): Overgrowth of C. albicans can cause vulvovaginal candidiasis. It is a common infection during pregnancy and in diabetic patients. Suppression of growth of vaginal lactobacilli by antimicrobial therapy also leads to overgrowth of C. albicans causing Candida vaginitis.
- Candidemia/disseminated infections
- Pneumonia
- Meningitis
Other diseases caused by Candida are paronychia, onychomycosis, endocarditis, eye infection, intertriginous candidiasis, etc. Disseminated infection of Candida and meningitis is seen mostly in immunocompromised and/or seriously ill patients.
Laboratory Diagnosis
Specimen depends on disease presentation. The common submitted sample includes; urine (in case of UTI), vaginal discharge (suspected cases of vaginal thrush) or CSF (when meningitis is suspected), sputum (when pneumonia* is suspected), and blood, or other exudates from the mucosal surface.

Note:Candidais not a cause of pneumonia, except possibly in leukemia or lung transplant patients or in neonates. Even in those cases, the growth ofCandidain lower respiratory specimens, regardless of species, does not correlate with disease. Yeasts are normal inhabitants of the mouth.
Microscopy and Staining
Candida yeast cells can be detected in unstained wet preparations or **Gram-stained preparations of sample.**In Gram-stained smears, Candida appears as gram-positive budding yeast cells (blastoconidia) and/or pseudohyphae showing regular constriction points.
Culture
Routine bacterial culture is sufficient for detecting Candida species whether aerobic blood culture bottle or agar media are used.
Candida albicans grows well on Sabouraud dextrose agar and in the most routinely used bacteriological media. Cream-colored pasty colonies usually appear after 24-48 hours of incubation at 25-37°C. The colonies have a distinctive yeast smell and the budding cells can be easily seen by direct microscopy in stained or unstained preparations.

Candida albicanscan be recognized by the formation of hyphal elements radiating from colonies on blood-containing media within 48 h of initial incubation. These colonies with “feet,” which can also resemble stars.
In Blood Agar, Candida albicans gives white, creamy-colored colonies, which can be mistaken for Staphylococcus spp. Whenever you are analyzing the culture report of ‘high vaginal swab,’ take extra care as the colony you are observing can be of Candida albicans instead of Staphylococcus aureus or vice versa (a quick solution for this is to perform wet mount or gram staining and observing under a microscope).
The carbohydrate fermentation test can differentiate C. albicans from other pathogenic species of Candida, such as *Candida tropicalis, Candida parapsilosis, Candida krusei,*and C. glabrata.

Germ tube test
Candida albicanscan be identified presumptively by a simple germ tube test.
Yeasts can be presumptively identified as Candida albicans when the appearance of “feet” on blood agar in 48 h and/or the germ tube is positive.
Molecular Methods
Molecular methods may be used to identify Candidaspecies within 60min from positive blood cultures when the Gram stain is suspicious forCandida spp., oval yeasts with or without pseudohyphae. A FISH methodusing PNA probes called the Yeast Traffic Light PNA FISH assay(AdvanDx, Woburn, MA), can differentiate the most commonly encounteredCandida spp. causing fungemia.
TEST YOUR UNDERSTANDING OF MYCOLOGY WITH OUR MCQs. TRY QUIZZES HERE
Treatment
Fluconazole is useful in the treatment of candidal infections. Posaconazole is used for the treatment of oropharyngeal candidiasis and the prevention of Candidainfections in immunocompromised individuals. Miconazole and clotrimazole are useful for topical therapy of Candidainfections.
You can find in-depth information aboutanti-fungal agents in this post.
References and further readings
- Amy L Leber. *Clinical Microbiology Procedures Handbook,*4th Edition (2016). ASM Press, Washington, DC.
- Procop, G. W., & Koneman, E. W. (2016). Koneman’s Color Atlas and Textbook of Diagnostic Microbiology(Seventh, International edition). Lippincott Williams and Wilkins.
- Tille, P. (2017). Bailey & Scott’s Diagnostic Microbiology (14 edition). Mosby.